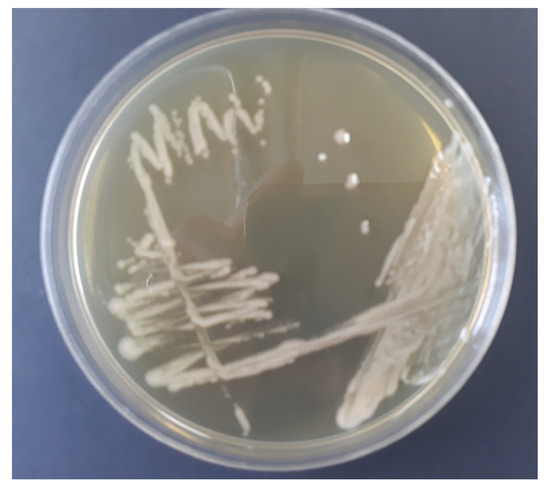

Abstract
The presence of nutrients in aquaculture water bodies causes serious problems for aquatic ecosystems, requiring the development of technical solutions to reduce their amounts. This work identifies some bacterial strains that are able to reduce nutrient quantities and studies the effect of antibiotics on bacterial growth, on the ability to form biofilms on different solid supports, and on the ability to reduce nutrients in aquaculture wastewater. Bacterial biofilm adhesion on different substrates depends on the surface properties of the substrate, on the bacterial types that form the biofilm, but also on biofilm–substrate interactions. The obtained results revealed the high capacity of biofilm-forming bacterial strains of Pseudomonas aeruginosa and Chromobacterium violaceum to eliminate up to 87% of nitrate and nitrite ions and up to 62% of phosphate ions in the presence of concentrations of 0.1–0.4 µg/mL of oxytetracycline antibiotic from aquaculture wastewater.
1. Introduction
In the last two decades, global human fish consumption increased rapidly to meet the demands of the growing population. According to OECD [1], in 2018, global fish production from aquaculture was ca. 115 million tons, which is about 2.7 times higher than in 2000, with an estimated marketplace of 264M USD. These higher amounts of food involve the use of intensive fish farming practices and non-environmentally friendly activities that generate nutrient pollution ([2,3], changes in biodiversity [4], result in the spread of diseases and involve the use of antibiotics and pesticides [5,6,7]. Nutrient pollution involves an over-enrichment of water with nitrogen and phosphorus. It results in eutrophication of aquatic ecosystems with adverse effects, such as the accumulation of organic carbon, the reduction of light penetration, and loss of submerged aquatic vegetation, producing an imbalance of nutrient ratios that create conditions, such as oxygen depletion, which are favorable for toxic algal blooms [8]. On the other hand, an efficient biological process of removing nitrogen from wastewater, implemented in most modern treatment plants, involves aeration of wastewater, which leads to high energy consumption (usually more than 50% of total costs) [9]. Therefore, it is necessary to develop nutrient removal technologies that do not involve aeration by developing physical, chemical, biological, or hybrid recovery technologies [10].
The physical, chemical, and biological methods conventionally used in wastewater treatment can also be used in aquaculture systems. The existence in aquaculture waters of a large amount of suspended and/or dissolved solids can lead to the depreciation of water quality, the reduction of the fishery resource, as well as the increase of water treatment costs [11]. Their removal is usually performed by sedimentation, followed by sand or mechanical filtration.
Reducing the volume of water used by combining recirculation with the addition of oxygen is a way to improve water usage and reduce the volume of spent effluent discharged into the environment because of improved treatment efficiency [12]. Under these conditions, water treatment system operations could be minimized, reducing the capital and operating costs [13].
The use of biochemical processes involving various microbial species in wastewater treatment processes, including those from aquaculture, is a field of research of great interest given its important practical applicability [3,14]. Numerous studies have shown that certain species of bacteria have a high capacity to degrade different types of micropolluants in wastewater. Thus, Pseudomonas aeruginosa, Pseudomonas putida, Acinetobacter sp., Artrobacter sp., Bacillus thuringiensis, etc. have been described as microorganisms suitable for the elimination of organic substances dissolved in water by adsorption processes on the surface of bacterial cells and their intracellular biotransformation [15,16]. This process results in new metabolites, and in controlled environmental conditions an easily decantable aggregate or film cellular material is made.
Moreover, biological methods using submerged biofilters, drainage filters, rotary biological contactors, and fluidized bed reactors are systems for organic matter oxidation, nitrification, or denitrification [17]. One main drawback of these methods is that they generate sludge, consume high amounts of energy and require frequent maintenance [18].
Antibiotics are a class of medicinal substances very commonly used both in human and veterinary medicine, as well as in agriculture and aquaculture [19], but which make a significant contribution to water contamination and environmental pollution, with long-term adverse effects on aquatic ecosystems [20]. Even in the case of advanced technologies, conventional biological wastewater treatment systems achieve low treatment rates of antibiotics in their effluents. These substances finally accumulate in the receiving waters, in sediment, plants, and animals.
The inhibitory action of antibiotics on microbial communities has been intensively studied in numerous scientific papers dealing with the efficiency of removal of these compounds from wastewater and the adaptation or resistance of microbial communities to different classes of antibiotics (β-lactams, tetracyclines, macrolides, sulfonamides, quinolones, etc.) [21]. In aquaculture, antibiotic-resistant bacteria pose a significant risk to public health because they create resistant genes that end up being transferred as such to human pathogens [22].
In this context, the present study identified new microbial strains with different degrees of resistance to oxytetracycline and used them in wastewater treatment, with high efficiency for the removal of nitrate, nitrite, and phosphate ions from aquaculture systems. The process of eliminating nutrients does not involve the use of aeration, which has the potential to greatly reduce the costs of wastewater treatment, making the process economically sustainable.
2. Materials and Methods
2.1. Bacterial Strains
A lyophilizate BFL 6000 HC (BioFuture Ltd., Dublin, Ireland) was used as the microbial consortium to identify new microbial species with wastewater treatment properties. The hydration of the lyophilizate was carried out in 100 mL sterile oxygen-enriched water (by bubbling with an air pump: pressure, 0.010 Pa; flow rate, 1.5 L min) in which an amount of 10 g lyophilizate was added. After 4 h, 10 mL of cooking oil and, after 12 h, nutrients (5 g fishmeal) were added. After 24 h, the inoculum was ready for use.
2.2. Taxonomic Identification
The microorganisms were grown on a Luria Broth (LB) liquid medium (in house prepared: in 1 L of distilled water were dissolved 10 g peptone, 5 g NaCl, 5 g yeast extract, followed by sterilization at 121 °C—Autoclave Systec VX-65 (Systec, Linden, Germany). The plates were seeded by the loop depletion technique, incubated for 24 h at 37 °C. After that, the same morphology bacteria were isolated by seeding in other plates with solid LB medium (obtained by addition of 12 g agar to the LB liquid medium).
The identification of isolated bacteria was made using the Analytical Profile Index system (API 20E, Biomerieux, Marcy l’Etoile, France), according to the procedure described in [23].
2.3. Antibiotic Resistance Assays
To identify the effect of the antibiotic (oxytetracycline for veterinary use—OTC commonly found in fish food) on the development and resistance of isolated bacteria, as well as the maximum concentration at which bacterial cells remain viable, different amounts of OTC were used (0.1–2 µg/mL). Bacterial development was assessed by tracing their growth curve from the optical density (OD) measurements (Tecan Genios Microplate Reader, Baldwin Park, NC, USA; l = 595 nm, T = 25–30 °C). After reading the optical density, a test for cell viability was performed with resazurin as follows: the incubated medium was transferred to Eppendorf tubes (1.5 mL of each tube), over which a volume of 30 µL of resazurin was added. Change in the color of the liquid from dark blue to pink indicates the existence of viable cells. The remaining 0.5 mL liquid was removed from the wells. To see if the bacterial strains adhered to the plate and if they formed a biofilm, 2 mL of distilled water and 50 µL of resazurin were added to the empty wells. The plate was placed on a Heidolph Titramax 101 shaker for 1 h at 300 rpm, after which OD measurements and cell viability testing were performed.
2.4. Biofilm Formation
Different types of commercially available biofilters (Table 1) were used as support for the formation of the biofilm from isolated bacteria in LB medium with and without OTC. Their chemical nature was determined from FTIR studies, using a JASCO FTIR-4200 (Jasco, Tokyo, Japan) coupled with an ATR accessory. The experiment consisted of introducing these biofilters into plastic tubes (Figure 1), in a volume of 20 mL of LB liquid synthetic medium and the bacterial inoculum with an OD of 0.5 McFarland. The tubes were stored in a shaker incubator for 7 days at a temperature of 30 °C, each species being analyzed separately for each biofilter type. The development of bacterial strains was also followed by determining the liquid medium’s optical density inoculated with bacteria, using the UV–Vis Jasco V-570 (Jasco, Tokyo, Japan) spectrophotometer.

Table 1.
Biofilters used as biofilm support.

Figure 1.
Filters immersed in the medium inoculated with the bacterial species and contaminated with oxytetracycline (OTC).
The synthetic medium, as a simulant for aquaculture waters, was obtained following the recipe of [24]: for one liter of medium a stock solution with pH = 5.8 was used, in which 10 mL of each solution of MgSO4 (23.6 g/100 mL), Ca (NO3)2 (13.6 g/100 mL), KHPO4 (13.6 g/mL), KNO3 (10.1 g/mL), 10 mL (H3BO3 nutrients (2.86 g/L), MgCl2 (1.82 g/L), ZnSO4 (0.22 g/L), NaMoO4 (0.09 g/L), CuSO4 (0.09 g/L)), 10 mL Fe-EDTA (0.121 g/250 mL FeCl3), EDTA (0.375 g/250 mL), 400 mL solution with yeast extract and bactopeptone, and 560 mL distilled water.
2.5. Evaluation of Bacterial Efficiency for the Reduction of Pollutants
The biofilm/biofilter system efficiency in reducing nitrite, nitrate, phosphorus, and ammonium ions from the synthetic water was assessed spectrophotometrically (UV–Vis V-570, Jasco, Tokyo, Japan) by the calibration curve method, using standard solutions of the corresponding ions. The initial concentrations of nitrite, nitrate, phosphorus, and ammonium ions used to assess their removal efficiency from synthetic water and the wavenumber used for their spectrophotometric quantification are presented in Table 2.

Table 2.
Initial concentrations of nitrite, nitrate, phosphorus, and ammonium ions.
2.6. Statistical Analysis
All analyses were performed in triplicate and the results were presented as the mean ± standard deviation (SD) of three independent experiments. The statistical significance was analyzed by a Student’s t-test. A value of p less than 0.05 was considered significant. The statistical analysis was performed with Microsoft Excel 2019 software (Microsoft, Redmond, WA, USA).
3. Results and Discussion
3.1. Isolation and Identification of Bacterial Species
BFL 6000HC is a well-known bioremediation solution that contains different microorganisms which produce certain enzymes able to degrade aliphatic, aromatic, and polar compounds from the environment, especially from hydrocarbons containing soils [29]. Due to the lack of information on the type of microorganisms present in BFL 6000HC, the lyophilizate was hydrated and inoculated into the plate in a solid LB medium to isolate and identify the existing bacterial strains. After the incubation period, the colonies formed were separated and plated on Petri dishes. Two types of colonies with different morphology appeared after the incubation period (Figure 2 and Figure 3).
Figure 2.
Colony I seeded plate.

Figure 3.
Colony II seeded plate.
The identification performed using the API 20E test [23] allowed the identification of two strains belonging to Pseudomonas aeruginosa (P. aeruginosa, Figure 4a) (% ID: 98%, colony (I)) and Chromobacterium violaceum (C. violaceum, Figure 4b) (% ID: 94%, colony (II)), respectively. Of the two isolated species, only the bacterial species grown on the first plate showed a fluorescence phenomenon upon exposure to UV light, which is characteristic of P. aeruginosa species [30].

Figure 4.
API20E test: (a) P. aeruginosa; (b) C. violaceum.
The Gram-negative mobile Proteobacteria represented by Pseudomonas aeruginosa, optionally anaerobic, have their habitat in soils, waters, human skin, etc. It grows both in normal and in lower oxygen atmospheres, thus colonizing many natural and artificial environments, metabolizes various organic substances, can decompose hydrocarbons, as well as reduce various compounds with nitrogen and heavy metals from residual water [31,32]. In addition, it can aggregate into biofilms [33] and possesses an intrinsic resistance to antibiotics [34]. Chromobacterium violaceum is a mobile, cocobacillary, Gram-negative, facultative anaerobic species with a high capacity to remove metal ions and azo compounds from industrial waters [35,36].
3.2. Bacterial Development in LB Medium
3.2.1. The Effect of Antibiotics on Bacterial Growth
For each isolated and identified bacterial species, a cell growth curve was performed in the presence of different OTC concentrations (Figure 5) to establish the influence of antibiotic concentration on their development.

Figure 5.
The influence of OTC concentration on P. aeruginosa (solid line) and C. violaceum (dashed line) growth (LB medium, normalized values, an average of three values).
Both bacterial strains have shown a similar growth trend in the presence of OTC, especially at OTC concentrations below 0.4 µg/mL. The data show that bacterial growth was higher at an OTC concentration of 0.2 µg/mL, with OD values close to those of OTC-free samples, followed by lower OD values, for OTC concentrations of 0.1 µg/mL and 0.4 µg/mL. At high OTC concentrations, the optical density values were consistently lower. The lag phase for P. aeruginosa is shorter than that of C. violaceum. The exponential phase started from the beginning (both for the sample without OTC and at 0.2 µg/mL) for P. aeruginosa and was 1–2 h (without OTC) and 7 h (0.2 µg/mL) for C. violaceum. At lower OTC concentrations, the period of bacterial accommodation was slightly longer, with the exponential phase starting after approximately 3 h (P. aeruginosa) and 7 h (C. violaceum) at 0.1 µg/mL, and 4 h (P. aeruginosa) and 9 h (C. violaceum) at 0.4 mg/mL. The stationary phase was also different depending on the bacterial species used, starting at approximately 5 h (P. aeruginosa) and 10 h (C. violaceum) until the end of the analysed period.
The obtained results are in line with Zhu et al. [37], who presented similar results in terms of the growth curve of P. aeruginosa in the presence of kanamycin. The bacteria were characterized by a short lag phase and they reached the stationary phase after approximately 6–8 h for the antibiotic-free sample. The growth rate was lower in the presence of the antibiotic; the growth phase was between 2 and 18 h, but at a concentration 100 times higher than the normal dosage of the antibiotic. This behavior is due to antibiotic-tolerance acquisition mediated by accumulating the redox-sensitive phenazine pyocyanin (PYO) [37].
Rahman et al. [38] studied the influence of anise star used both as anti-QS (quorum sensing) and anti-biofilm forming agent on the development of P. aeruginosa and C. violaceum, and their results were similar to those obtained in our study regarding the initial lag phases of 4–7 h, respectively, 0–2 h.
3.2.2. Biofilm Formation and Retention Capacity Evaluation
Biofilm formation was also evaluated by OD measurements of the washing waters, in which the biofilters from the LB medium were immersed. The analysis was performed after ultrasonically treating the biofilters for 30 s, which was sufficient for the detachment of the bacterial biofilm from the surface of the filter, without affecting viability, and this was confirmed by the resazurin cell viability test.
The cellular viability test of the studied bacterial strains confirmed the data from the growth curves, observing a high viability in both bacterial strains, at all OTC concentrations studied, with a slight decrease in color intensity at a concentration of 0.4 µg/mL (Figure 6).

Figure 6.
Resazurin test—biofilm of P. aeurginosa and C. violaceum: LB medium (A1/C1); without OTC (A2, A3/C2, C3); 0.1 µg/mL OTC (A4, A5, A6/C4, C5, C6); 0.2 µg/mL OTC (B1, B2, B3/D1, D2, D3); 0.4 µg/mL OTC (B4, B5, B6/D4, D5, D6).
Bacterial biofilm adhesion properties with respect to different substrates depend on the surface properties of the substrate (e.g., chemical nature, roughness, hydrophobicity, hydrophilicity, shape, and size), on the bacterial types that form the biofilm, but also on biofilm–substrate interactions (e.g., physical, chemical, electrochemical).
FTIR spectroscopy is a common tool used to establish the chemical structure of various organic and inorganic materials by identifying the vibration of chemical bonds of various molecules. The ATR/FTIR spectra recorded on the used biofilters are presented in Figure 7, and are characteristic of plastic materials based on:

Figure 7.
ATR/FTIR spectra recorded on used biofilter materials: (a) polypropylene; (b) polyethylene.
- −
- Polypropylene (Figure 7a)—the peaks at 2830, 2915, and 2952 cm−1 are due to symmetric and asymmetric stretching vibrations of —CH2— and asymmetric stretching of CH3; the peaks at 1449 cm−1 and 1372 cm−1 are due to CH3 symmetric bending vibration; 994 and 971 cm−1 are due to CH3 rocking vibrations [39,40];
- −
- Polyethylene (Figure 7b)—the peaks at 2830 and 2915 cm−1 are due to symmetric and asymmetric stretching vibrations of —CH2—, 1468 cm−1 due to —CH2—bending deformation, and 718 cm−1 due to CH rocking deformation [41,42]. The low absorption (for F3 and F4) or the absence of the absorption (for F5) at 1373 cm−1 (due to methyl CH3 vibration groups) is a clear indication that the filter materials are based on high density polyethylene (HDPE). The FTIR bands at about 670, 1000 cm−1 (for F3 and F4) could be assigned to the presence of chlorine in the material structure, and the band a 3310 cm−1 (for F5) is assigned to bonded OH due to material ageing [43].
These interactions are also dependent on the physicochemical characteristics of the fluid (e.g., pH, temperature) in which the substrate is introduced [44]. The ability of both strains to form biofilms on various substrates is due to the synthesis of different molecules, such as the synthesis of three alginate exopolysaccharides, Psl and Pel [45] by P. aeruginosa and N-acetyl-d-glucosamine monomer by C. violaceum [46].
In this paper, the bacterial biofilm retention efficiency for the six types of biofilters was evaluated gravimetrically by determining the amount of biofilm deposited on the support, both in the absence and presence of OTC (Table 3). OTC is a common antibiotic in aquaculture [47] and potentially has a harmful influence on bacterial species development with water purification potential. Therefore, bacterial strain choice with intrinsic resistance to OTC is essential for developing treatment solutions based on them.

Table 3.
Variation of biofilm mass in LB medium.
The influence of OTC antibiotics on the development of bacteria from the species P. aeruginosa, respectively, C. violaceum, was tested using different OTC concentrations between 0.1–0.4 µg/mL, based on the results obtained in the evaluation of the bacterial growth curve.
The influence of the solid substrate on the retention and formation capacity of the biofilm and the type of bacteria involved in the formation of the biofilm, in the absence of OTC, is especially evident in the case of F5 and F6 filters for both species used. As shown in Table 3, the ability of C. violaceum to adhere to the solid support is higher than that of P. aeruginosa, possibly due to favorable interactions with the biofilter material.
These results are crucial in industrial practice, particularly in deciding on the type of biofilter that can provide an efficient wastewater treatment capacity, depending on the type of biofilm-forming bacterial species [48].
In the presence of OTC, experimental data show a general trend of decreasing the amount of biofilm with increasing antibiotic concentration for all study filters. However, at a concentration of 0.1 µg/mL, the amount of biofilm formed was much less than in the case of experiments performed in the presence of the antibiotic.
For P. aeruginosa (Table 3), the highest microbial mass retention capacity is observed for F5 and F6 biofilters, in the absence of OTC. Starting with 0.2 µg/mL OTC, a sharp decrease in the amount of biofilm formed is observed. A similar behavior was observed for the C. violaceum strain, with the most considerable amount of biofilm retained on the F1, F5, and F6 biofilters. These results show the complexity of the phenomena involved in the formation of the biofilm and the importance of the nature of the interactions between the biofilm and the solid support.
Vanysacker et al. [49] obtained similar results when studying the development of P. aeruginosa on membranes with different chemical characteristics, highlighting a non-repetitive effect of the membrane on the adhesion capacity of the biofilm. At the same time, the increase in the amount of biofilm with the increase in antibiotic concentration suggests an adaptation of bacterial species to OTC by developing mechanisms to prevent the antimicrobial effect of the antibiotic [20,50]. Therefore, the use of P. aeruginosa and C. violaceum strains may have a high potential for biotreatment of aquaculture wastewater, even in waters contaminated with antibiotics.
3.2.3. Optical Density Measurements
The influence of OTC concentration on bacterial growth and the retention capacity of each biofilter was also evaluated by measuring the optical density (correlated with the cell density in the medium) of the liquid represented by the antibiotic-contaminated culture after removing the filters. This bacterial mass was not retained on the filters found in the culture medium.
The results are similar to those obtained in experiments based on the gravimetric determination of the amount of biofilm formed. Thus, for P. aeruginosa, a slight decrease of the optical density values is observed (Figure 8) by adding antibiotics at low concentrations (0.1–0.2 µg/mL), followed by an increase in OD at higher OTC concentrations. This increase could also be attributed to the bacterial species’ exposure to the antibiotic in the environment and the antimicrobial effect of OTC being more pronounced at lower concentrations [20,22].

Figure 8.
OD variation of the LB medium solution of P. aeruginosa with OTC concentration.
The behavior of C. violaceum (Figure 9) is different to that of P. aeruginosa, a tendency for the continuous increase of OD values with increasing OTC concentration, for all types of biofilters used, having been observed. This suggests that the development of C. violaceum is less influenced by the presence of OTC, which even has a stimulating effect.

Figure 9.
OD variation of the LB medium solution of C. violaceum with OTC concentration.
3.3. Bacteria Development in Synthetic Medium
3.3.1. The Effect of Antibiotics on Bacterial Growth
To study how the identified bacterial strains react to a specific culture medium, P. aeruginosa and C. violaceum were cultured in a synthetic medium. For this, a growth curve for these bacteria was generated, resulting from the variation in the optical density (OD) of the synthetic medium, both in the absence and in the presence of OTC, at different concentrations (Figure 10). For comparison, a control solution represented by the synthetic medium without inoculum or OTC was used.

Figure 10.
The influence of OTC concentration on P. aeruginosa (solid line) and C. violaceum (dashed line) growth (synthetic medium, normalized values, an average of three values).
The experimental results obtained for both bacterial species show a behaviour similar to that observed in the case of inoculation in LB medium, the highest cell density obtained at a concentration of 0.2 µg/mL, followed by 0.1 and 0.4 µg/mL, respectively. It should be noted that the maximum OD values are lower in the synthetic media, with up to 60% in the case of C. violaceum, compared to the LB nutritive medium, which indicates a lower cell density in solution. Moreover, it is observed that the accommodation period is shorter in the synthetic medium for C. violaceum at an OTC concentration of 0.2 µg/mL. At the other OTC concentrations, the accommodation periods were similar to those in LB medium.
3.3.2. Biofilm Formation and Retention Capacity Evaluation
The cellular viability test of the studied bacterial strains confirmed the data from the growth curves in a synthetic medium, a high viability in both bacterial strains up to 0.2 µg/mL having been observed. Unlike the LB medium, in the synthetic medium, the bacterial strains have a much lower viability at 0.4 µg/mL (Figure 11), justifying the choice of a concentration of 0.2 µg/mL as the maximum OTC concentration for the continuation of the experiments.

Figure 11.
Resazurin test—biofilm of P. aeruginosa and C. violaceum: synthetic medium (A1/C1); without OTC (A2, A3/C2, C3); 0.1 µg/mL OTC (A4, A5, A6/C4, C5, C6); 0.2 µg/mL OTC (B1, B2, B3/D1, D2, D3); 0.4 µg/mL OTC (B4, B5, B6/D4, D5, D6).
Like the LB medium, the six types of biofilters were maintained in the synthetic medium contaminated with the OTC concentration which was most favourable for developing bacterial strains (0.2 µg/mL). After 7 days at 30 °C, they were extracted from the synthetic solution, by gravimetric methods (Table 4) and optical methods (Figure 12), and the retention efficiency as well as the retention biomass were both calculated.

Table 4.
Variation of biofilm mass in synthetic medium.

Figure 12.
Influence of filter type on cell density of bacterial strains in synthetic medium (OTC: 0.2 µg/mL).
The experimental results (Table 4) show that the F1, F2, F3, F5, and F6 biofilters retained a higher amount of bacterial mass of C. violaceum, except for the F5 biofilter, which was more efficient for the P. aeruginosa strain. Both bacterial species developed better in the synthetic medium. Although the cell density is lower in the synthetic medium solution than in the LB medium, the biofilm amount deposited on the biofilters is significantly higher. This effect can be attributed to the nutrients present in the synthetic environment, especially nitrogen compounds (they are denitrifying bacteria [51]), which seem to strengthen these strains, conducing to a better adhesion to the surface of biofilters. Consequently, this may lead to an increase in the bioremediation potential of these biofilm/biofilter systems in the purification of aquaculture waters, even in conditions of antibiotic-contaminated waters.
The biofilm retention capacity on the surface of biofilters, exposed in synthetic medium, was determined after the filter extraction, ultrasonic treatment in water, and the washing waters optical density evaluation (Figure 13).

Figure 13.
Optical density of the washing waters after ultrasonication.
A higher level of bacterial mass deposited on biofilters ensures a more advanced degree of bioremediation of wastewater, the bacterial mass being the substrate that consumes nutrients and pollutants in the water. With this in mind, the bioremediation potential of biofilters was higher for C. violaceum than P. aeruginosa.
3.4. Strain Efficiency and Nutrient Content Removal in Aquaculture Wastewaters
From the analysis of the experimental data on the elimination efficiency of different types of ions (Table 5), it is observed that, compared to the initial concentration of 162.76 µg NO3−-N existing in the culture medium without inoculum, the presence of bacteria resulted in a sharp decrease in nitrate ion concentration to a minimum of 22.6 µg NO3−-N for the P. aeruginosa/F1 system, and 24.1 µg NO3−-N for the C. violaceum/F6 system. A lesser reduction in nitrate concentration, i.e., lower bacterial activity, was recorded for both the P. aeruginosa/F2 and C. violaceum/F2 systems, all other biofilters proving relatively good bioremediation efficiencies in terms of nitrate consumption by the bacterial species used.

Table 5.
Removal efficiency of different ions by the biofilm/biofilter systems.
The reduction of nitrate concentrations in synthetic culture media is explained by the fact that both types of P. aeruginosa and C. violaceum strains are denitrifying bacteria, using nitrogen in specific metabolic processes, thus participating in the elimination of this nutrient from the aqueous environment [51]. These results indicate that the studied biofilters are effective devices in fixing bacterial mass capable of consuming nitrates from water and can be used successfully in practical bioremediation applications [48], providing a degree of nitrate reduction of about 86% [52].
In the case of nitrite ions, the highest reduction efficiency of up to 10 times was observed for the F4 biofilter (~87%), for both bacterial species. The bacterial species fixed on the surface of the studied filters have a very high metabolic activity in terms of the use of nitrites as a source of nitrogen in the development of microbial biomass, as they are very efficient in wastewater and aquaculture treatment processes that involve high concentrations of nitrites [48].
In the case of ammonium ions, experimental data indicate that inoculated culture media show the inefficiency of bacteria/biofilters in reducing ammoniacal nitrogen, which means that these bacterial species do not use ammonium in their metabolic processes. A slight reduction in ammoniacal nitrogen was recorded for the P. aeruginosa/F6 system and the C. violaceum/F5 system, in the range of 10–12%. However, these reductions are insignificant for the efficiency of water biotreatment processes. In practical applications, other denitrifying bacterial species must be used as biological means of removing ammoniacal nitrogen from wastewater, working in synergy with high-activity denitrifying bacterial species for nitrate and nitrite nitrogen [53].
In the case of phosphate ions, it is observed that all biofilters used in the culture media inoculated with the two bacterial species caused a reduction of about 62% in the level of phosphates in the environment, the most efficient systems having been shown to be P. aeruginosa/F5 and C. violaceum/F3. From the obtained results, it can be concluded that both microbial species used in the experiments reported herein to evaluate the efficiency of phosphorus removal have shown high activity in removing phosphorus from culture media, so they are phosphate-reducing bacterial species, able to use phosphate ions in their metabolic processes, and can therefore be employed in industrial practices for the biotreatment of wastewaters loaded with phosphates.
4. Conclusions
The bioremediation efficiency of aquaculture wastewaters was evaluated using six common types of biofilters, in LB and synthetic media, inoculated with two types of bacteria, commonly found in wastewater, namely, Pseudomonas aeruginosa and Chromobacterium violaceum, in the presence of oxytetracycline.
The two bacterial strains exhibited different behavior to OTC exposure, evidenced by their growth curve characteristics, as well as different adhesion capacities to the tested biofilter solid substrates.
These biofilters were efficient in fixing the bacterial mass, which consumed nitrite, nitrate, and phosphate micropollutants from aquaculture wastewaters and can be used successfully in practical bioremediation applications. The bacterial strains biofilm/filter systems used in this study showed a reduction in aquaculture wastewater of up to 87% for nitrate and nitrite ions and of up to 62% percent for phosphate ions, which is higher than the efficiency of other bacterial species reported in the literature (usually between 30–60%). In contrast, the experimental results indicated an inefficiency of these bacterial species to reduce ammonium-N.
These results provide solid evidence for the implementation of these biofilm/filter systems in the large-scale treatment of aquaculture waters, with a major positive impact on aquatic life. Moreover, the practical applicability of these results can be extended to the treatment, in an energetically sustainable manner, with low maintenance and implementation costs, of other types of wastewater, including industrial and municipal wastewaters.
Author Contributions
Conceptualization, N.-O.N. and O.C.; methodology, N.-O.N., E.-M.L., I.A.I. and G.A.R.; investigation, N.-O.N. and E.-M.L.; data curation, N.-O.N.; writing—original draft preparation, N.-O.N. and E.-M.L.; writing—review and editing, N.-O.N., O.C., E.-M.L., I.A.I. and G.A.R.; supervision, N.-O.N. and O.C.; project administration, E.-M.L.; funding acquisition, E.-M.L. and G.A.R. All authors have read and agreed to the published version of the manuscript.
Funding
Financial support was provided by the Romanian Ministry of Research, Innovation and Digitization through contracts PN 19310101-46N/2019, 446PED/2020 and 25PFE/2021 (between National R&D Institute for Electrical Engineering ICPE-CA and Romanian Ministry of Research, Innovation and Digitization). The support of the COST Programme through the COST Action CA19123/2020—PHOENIX is also acknowledged. During this study, I.A.I. has been a Bill & Melinda Gates Foundation grantee, supported under grant No.: INV006499.
Institutional Review Board Statement
Not applicable.
Informed Consent Statement
Not applicable.
Data Availability Statement
Data are available upon request from the corresponding author.
Conflicts of Interest
The authors declare no conflict of interest.
References
- OECD. Aquaculture Production (Indicator); OECD Publishing: Paris, France, 2021. [Google Scholar] [CrossRef]
- Zhang, K.; Yu, D.; Li, Z.; Xie, J.; Wang, G.; Gong, W.; Yu, E.; Tian, J. Influence of eco-substrate addition on organic carbon, nitrogen and phosphorus budgets of intensive aquaculture ponds of the Pearl River, China. Aquaculture 2020, 520, 734868. [Google Scholar] [CrossRef]
- John, E.M.; Krishnapriya, K.; Sankar, T.V. Treatment of ammonia and nitrite in aquaculture wastewater by an assembled bacterial consortium. Aquaculture 2020, 526, 735390. [Google Scholar] [CrossRef]
- Islam, M.; Yasmin, R. Impact of Aquaculture and Contemporary environmental issues in Bangladesh. Int. J. Fish. Aquat. Stud. 2017, 5, 100–107. [Google Scholar]
- Pérez-Sánchez, T.; Mora-Sánchez, B.; Balcázar, J.L. Biological Approaches for Disease Control in Aquaculture: Advantages, Limitations and Challenges. Trends. Microbiol. 2018, 26, 896–903. [Google Scholar] [CrossRef]
- Choi, S.; Sim, W.; Jang, D.; Yoon, Y.; Ryu, J.; Oh, J.; Woo, J.S.; Kim, Y.M.; Lee, Y. Antibiotics in coastal aquaculture waters: Occurrence and elimination efficiency in oxidative water treatment processes. J. Hazard. Mater. 2020, 396, 122585. [Google Scholar] [CrossRef]
- Moe, S.J.; Hjermann, D.Ø.; Ravagnan, E.; Bechmann, R.K. Effects of an aquaculture pesticide (diflubenzuron) on non-target shrimp populations: Extrapolation from laboratory experiments to the risk of population decline. Ecol. Model. 2019, 413, 108833. [Google Scholar] [CrossRef]
- OECD. Agriculture’s Impact on Aquaculture: Hypoxia and Eutrophication in Marine Waters; OECD Publishing: Paris, France, 2012. [Google Scholar]
- Lozano Avilés, A.B.; Del Cerro Velázquez, F.; Llorens Pascual Del Riquelme, M. Methodology for Energy Optimization in Wastewater Treatment Plants. Phase I: Control of the Best Operating Conditions. Sustainability 2019, 11, 3919. [Google Scholar] [CrossRef]
- Beckinghausen, A.; Odlare, M.; Thorin, E.; Schwede, S. From removal to recovery: An evaluation of nitrogen recovery techniques from wastewater. Appl. Energy 2020, 263, 114616. [Google Scholar] [CrossRef]
- Bilotta, G.S.; Brazier, R.E. Understanding the influence of suspended solids on water quality and aquatic biota. Water Res. 2008, 42, 2849–2861. [Google Scholar] [CrossRef]
- Cripps, S.J.; Bergheim, A. Solids management and removal for intensive land-based aquaculture production systems. Aquacult. Eng. 2000, 22, 33–56. [Google Scholar] [CrossRef]
- Capodaglio, A.; Olsson, G. Energy Issues in Sustainable Urban Wastewater Management: Use, Demand Reduction and Recovery in the Urban Water Cycle. Sustainability 2019, 12, 266. [Google Scholar] [CrossRef]
- Lananan, F.; Abdul Hamid, S.H.; Din, W.N.S.; Ali, N.A.; Khatoon, H.; Jusoh, A.; Endut, A. Symbiotic bioremediation of aquaculture wastewater in reducing ammonia and phosphorus utilizing Effective Microorganism (EM-1) and microalgae (Chlorella sp.). Int. Biodeterior. Biodegrad. 2014, 95, 127–134. [Google Scholar] [CrossRef]
- Chen, Y.; Zhang, C.; Li, Y. Ultrasonic-assisted Biodegradation of Endocrine Disrupting Compounds in Soil by Pseudomonas putida: The Importance of Rhamnolipid for Intermediate Product Degradation. Chem. Res. Chin. Univ. 2017, 33, 179–186. [Google Scholar] [CrossRef]
- Kanaujiya, D.K.; Paul, T.; Sinharoy, A.; Pakshirajan, K. Biological Treatment Processes for the Removal of Organic Micropollutants from Wastewater: A Review. Curr. Pollut. Rep. 2019, 5, 112–128. [Google Scholar] [CrossRef]
- Jin, X.; Zhao, Z.; Qin, Z.; Lu, D.; Liang, S.-X. Distribution and degradation of organic matter with different molecular weight in an A2/O treatment system. Appl. Water Sci. 2017, 7, 3497–3502. [Google Scholar] [CrossRef][Green Version]
- Gutierrez-Wing, M.T.; Malone, R.F. Biological filters in aquaculture: Trends and research directions for freshwater and marine applications. Aquacult. Eng. 2006, 34, 163–171. [Google Scholar] [CrossRef]
- Schar, D.; Klein, E.Y.; Laxminarayan, R.; Gilbert, M.; Van Boeckel, T.P. Global trends in antimicrobial use in aquaculture. Sci. Rep. 2020, 10, 21878. [Google Scholar] [CrossRef]
- Çetecioglu, Z.; Atasoy, M. Biodegradation and inhibitory effects of antibiotics on biological wastewater treatment systems. In Toxicity and Biodegradation Testing, Methods in Pharmacology and Toxicology; Bidola, E., Montagnolli, R., Eds.; Humana Press: New York, NY, USA, 2018; pp. 29–55. [Google Scholar]
- Hassan, M.; Zhu, G.; Lu, Y.-z.; Al-Falahi, A.H.; Lu, Y.; Huang, S.; Wan, Z. Removal of antibiotics from wastewater and its problematic effects on microbial communities by bioelectrochemical Technology: Current knowledge and future perspectives. Environ. Eng. Res. 2021, 26, 190400–190405. [Google Scholar] [CrossRef]
- Romero, J.; Gloria, C.; Navarrete, P. Antibiotics in Aquaculture—Use, Abuse and Alternatives. In Health and Environment in Aquaculture; Carvalho, E., Ed.; BoD—Books on Demand: Norderstedt, Germany, 2012; pp. 159–198. [Google Scholar]
- Libretex. API20E Multitest Strip. Available online: https://bio.libretexts.org/Demos%2C_Techniques%2C_and_Experiments/Microbiology_Labs_I/43%3A_API-20E_multitest_strip (accessed on 25 January 2022).
- Cowgill, U.M.; Milazzo, D.P. The Culturing and Testing of Two Species of Duckweed; Cowgill, U.M., Williams, L.R., Eds.; ASTM International: West Conshohocken, PA, USA, 1989; pp. 379–391. [Google Scholar]
- Cataldo, D.A.; Maroon, M.; Schrader, L.E.; Youngs, V.L. Rapid colorimetric determination of nitrate in plant tissue by nitration of salicylic acid. Commun. Soil. Sci. Plant Anal. 1975, 6, 71–80. [Google Scholar] [CrossRef]
- Porche, M. Spectrophotometric Determination of Nitrite by Derivatization with Captopril. Master’s Thesis, Miami University, Oxford, OH, USA, 2014. Available online: http://rave.ohiolink.edu/etdc/view?acc_num=miami1399075201 (accessed on 25 January 2022).
- Koroleff, F. Determination of ammonia. In Methods of Seawater Analysis; Wiley-VCH: Weinheim, Germany, 1983. [Google Scholar]
- Fiske, C.H.; Subbarow, Y. The colorimetric determination of phosphorus. J. Biol. Chem. 1925, 66, 375–400. [Google Scholar] [CrossRef]
- Pascale, G.; Popescu, R.; Stancu, C.; Nica, E.; Gabor, V.D.; Crăciun, N.; Stoian, G. Adaptative Responses of Two Fabaceae Species to Heavy Crude Oil of Polluted and Remediated Soils. Int. J. Agric. Innov. Res. 2016, 5, 142–148. [Google Scholar]
- Brodsky, M.H.; Nixon, M.C. Rapid Method for Detection of Pseudomonas aeruginosa on MacConkey Agar under Ultraviolet Light. Appl. Microbiol. 1973, 26, 219–220. [Google Scholar] [CrossRef]
- An, Q.; Deng, S.; Xu, J.; Nan, H.; Li, Z.; Song, J.-L. Simultaneous reduction of nitrate and Cr(VI) by Pseudomonas aeruginosa strain G12 in wastewater. Ecotoxicol. Environ. Saf. 2020, 191, 110001. [Google Scholar] [CrossRef] [PubMed]
- Kamika, I.; Momba, M.N.B. Assessing the resistance and bioremediation ability of selected bacterial and protozoan species to heavy metals in metal-rich industrial wastewater. BMC Microbiol. 2013, 13, 28. [Google Scholar] [CrossRef]
- Thi, M.T.T.; Wibowo, D.; Rehm, B.H.A. Pseudomonas aeruginosa Biofilms. Int. J. Mol. Sci. 2020, 21, 8671. [Google Scholar] [CrossRef]
- Delgado, M.C.G.; Garcia-Mayorgas, A.D.; Rodriguez, F.; Ibarra, A.; Casal, M. Susceptibility and resistence of Pseudomonas aeruginosa to antimicrobial agents. Rev. Esp. Quimioter. 2007, 20, 230–233. [Google Scholar]
- Verma, K.; Saha, G.; Kundu, L.M.; Dubey, V.K. Biochemical characterization of a stable azoreductase enzyme from Chromobacterium violaceum: Application in industrial effluent dye degradation. Int. J. Biol. Macromol. 2019, 121, 1011–1018. [Google Scholar] [CrossRef]
- Faramarzi, M.A.; Stagars, M.; Pensini, E.; Krebs, W.; Brandl, H. Metal solubilization from metal-containing solid materials by cyanogenic Chromobacterium violaceum. J. Biotechnol. 2004, 113, 321–326. [Google Scholar] [CrossRef] [PubMed]
- Zhu, K.; Chen, S.; Sysoeva, T.A.; You, L. Universal antibiotic tolerance arising from antibiotic-triggered accumulation of pyocyanin in Pseudomonas aeruginosa. PLoS Biol. 2019, 17, e3000573. [Google Scholar] [CrossRef] [PubMed]
- Rahman, M.R.; Lou, Z.; Zhang, J.; Yu, F.; Timilsena, Y.P.; Zhang, C.; Zhang, Y.; Bakry, A.M. Star Anise (Illicium verum Hook. f.) as Quorum Sensing and Biofilm Formation Inhibitor on Foodborne Bacteria: Study in Milk. J. Food Prot. 2017, 80, 645–653. [Google Scholar] [CrossRef] [PubMed]
- Fang, J.; Zhang, L.; Sutton, D.; Wang, X.G.; Lin, T. Needleless Melt-Electrospinning of Polypropylene Nanofibres. J. Nanomater. 2012, 2012, 382639. [Google Scholar] [CrossRef]
- Lungulescu, M.E.; Zaharescu, T.; Plesa, I.; Podina, C. Thermal and radiation stability of polyolefins modified with silica nanoparticles. J. Optoelectron. Adv. Mater. 2014, 16, 719–725. [Google Scholar]
- Lungulescu, E.-M. Contributions to the Study and Characterization of Degradation Processes of the Insulating Polymeric Materials in High-Energy Radiation Fields. Ph.D. Thesis, University of Bucharest, Bucharest, Romania, 2014. [Google Scholar]
- Gulmine, J.V.; Janissek, P.R.; Heise, H.M.; Akcelrud, L. Polyethylene characterization by FTIR. Polym. Test. 2002, 21, 557–563. [Google Scholar] [CrossRef]
- Ilie, S.; Setnescu, R.; Lungulescu, E.M.; Marinescu, V.; Ilie, D.; Setnescu, T.; Mares, G. Investigations of a mechanically failed cable insulation used in indoor conditions. Polym. Test. 2011, 30, 173–182. [Google Scholar] [CrossRef]
- Garrett, T.R.; Bhakoo, M.; Zhang, Z. Bacterial adhesion and biofilms on surfaces. Prog. Nat. Sci. 2008, 18, 1049–1056. [Google Scholar] [CrossRef]
- Ghafoor, A.; Hay, I.D.; Rehm, B.H. Role of exopolysaccharides in Pseudomonas aeruginosa biofilm formation and architecture. Appl. Environ. Microbiol. 2011, 77, 5238–5246. [Google Scholar] [CrossRef] [PubMed]
- Becker, S.; Soares, C.; Porto, L.M. Computational analysis suggests that virulence of Chromobacterium violaceum might be linked to biofilm formation and poly-NAG biosynthesis. Genet. Mol. Biol. 2009, 32, 640–644. [Google Scholar] [CrossRef] [PubMed]
- Carson, M.C.; Bullock, G.; Bebak-Williams, J. Determination of oxytetracycline residues in matrixes from a freshwater recirculating aquaculture system. J. AOAC Int. 2002, 85, 341–348. [Google Scholar] [CrossRef] [PubMed]
- Schreier, H.J.; Mirzoyan, N.; Saito, K. Microbial diversity of biological filters in recirculating aquaculture systems. Curr. Opin. Biotechnol. 2010, 21, 318–325. [Google Scholar] [CrossRef]
- Vanysacker, L.; Denis, C.; Declerck, P.; Piasecka, A.; Vankelecom, I.F. Microbial adhesion and biofilm formation on microfiltration membranes: A detailed characterization using model organisms with increasing complexity. Biomed. Res. Int. 2013, 2013, 470867. [Google Scholar] [CrossRef]
- Baquero, F.; Martínez, J.-L.; Cantón, R. Antibiotics and antibiotic resistance in water environments. Curr. Opin. Biotechnol. 2008, 19, 260–265. [Google Scholar] [CrossRef] [PubMed]
- Cydzik-Kwiatkowska, A.; Wojnowska-Baryla, I. Nitrogen-converting communities in aerobic granules at different hydraulic retention times (HRTs) and operational modes. World J. Microbiol. Biotechnol. 2015, 31, 75–83. [Google Scholar] [CrossRef] [PubMed]
- Peng, X.; Guo, F.; Ju, F.; Zhang, T. Shifts in the microbial community, nitrifiers and denitrifiers in the biofilm in a full-scale rotating biological contactor. Environ. Sci. Technol. 2014, 48, 8044–8052. [Google Scholar] [CrossRef] [PubMed]
- Schneider, O.; Sereti, V.; Eding, E.H.; Verreth, J.A.J. Analysis of nutrient flows in integrated intensive aquaculture systems. Aquacult. Eng. 2005, 32, 379–401. [Google Scholar] [CrossRef]
Publisher’s Note: MDPI stays neutral with regard to jurisdictional claims in published maps and institutional affiliations. |
© 2022 by the authors. Licensee MDPI, Basel, Switzerland. This article is an open access article distributed under the terms and conditions of the Creative Commons Attribution (CC BY) license (https://creativecommons.org/licenses/by/4.0/).





